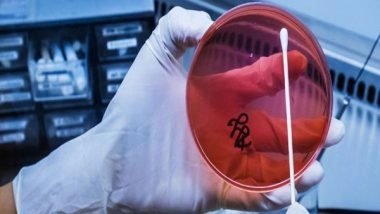
World News | Asia-Pacific Countries Sound Alarm and Commit to Tackling Antimicrobial Resistance

Geneva [Switzerland], May 29 (ANI): Health leaders from countries and areas of the World Health Organisation (WHO) South-East Asia and Western Pacific Regions sounded the alarm and committed to work together to more effectively tackle antimicrobial resistance (AMR), WHO informed in a press release on Wednesday.
They endorsed a joint position paper on AMR in the human health sector in the Asia-Pacific region at an event held on the sidelines of the World Health Assembly in Geneva, Switzerland.
Initiated by the Government of Japan, and endorsed by a total of 25 Asia-Pacific countries, namely, Australia, Bangladesh, Bhutan, Cambodia, Democratic People's Republic of Korea, Indonesia, Japan, Lao People's Democratic Republic, Malaysia, Maldives, Mongolia, Nauru, Nepal, New Zealand, Palau, Papua New Guinea, Philippines, Republic of Korea, Singapore, Solomon Islands, Sri Lanka, Thailand, Timor Leste, Tonga and Vanuatu, the joint position paper expresses the determination of leaders from Asia and the Pacific to accelerate action on AMR in the human health sector over the next five years.
To foster collaboration and partnership with the rest of the world, the paper will be taken to the United Nations High-Level Meeting on Antimicrobial Resistance in New York in September 2024, the release added.
Also Read | Papua New Guinea Landslide: India Announces Aide of USD 1 Million for Landslide-Hit Nation.
The misuse and overuse of antimicrobials - especially antibiotics - in humans, animals and plants are driving the rise of drug-resistant infections. This makes common infections harder to treat and medical procedures and treatments, such as surgery and chemotherapy, much riskier.
Other factors that contribute to the emergence and spread of drug-resistant infections include a lack of clean water, sanitation and hygiene (WASH) and inadequate infection prevention and control. These promote the spread of microbes that are resistant to treatment in health facilities and communities.
AMR is a rising threat to health and development globally and to countries and areas of the WHO South-East Asia and Western Pacific Regions - home to nearly half of the world's population. In 2019, AMR was the cause of an estimated 7,00,000 deaths in the two regions, representing more than half of the global deaths caused by AMR.
Beyond the immediate threat to human health, AMR also threatens global and national economies. For instance, unless it can be effectively addressed, countries and areas of the WHO Western Pacific Region are expected to face excess economic costs of up to USD 148 billion due to AMR between 2020 and 2030.
"The endorsement of this joint position paper by 25 countries and areas across the Asia-Pacific region shows their determination to lead global efforts to tackle this fundamental threat to health and economies," said Saia Ma'u Piukala, WHO Regional Director for the Western Pacific.
World leaders are recognising the urgency of addressing antimicrobial resistance. "To address the urgent issue of AMR, which is referred to as a 'silent pandemic', we have to further accelerate international cooperation and leadership in response to it," said Shiozaki Akihisa, Parliamentary Vice-Minister of Health, Labour and Welfare, Japan.
Saima Wazed, WHO Regional Director for South-East Asia, described the action taken today: "This week, health ministers at the World Health Assembly will discuss how to accelerate the response to AMR. By making this commitment today, and taking it to the United Nations General Assembly High-Level Meeting on AMR in September, countries from Asia and the Pacific are making clear that they recognise the urgency of action, and they are demonstrating commitment to drive change from our part of the world."
In addition to endorsement of the joint position paper on AMR in the human health sector in the Asia Pacific region, this week the World Health Assembly will consider a resolution (proposed by Thailand along with Australia, Brazil, Canada, Chile, China, Ecuador, Egypt, the European Union and its 27 Member States, Georgia, Indonesia, Japan, Kenya, Kuwait, Malaysia, Mexico, Norway, Oman, Panama, Philippines, Qatar, Saudi Arabia, South Africa, Switzerland, Thailand, United Kingdom of Great Britain and Northern Ireland and United States of America).
Recognising the need for a One Health approach - involving human and veterinary medicine, agriculture, aquaculture, the environment and other sectors - the draft resolution calls on WHO, the Food and Agriculture Organisation of the United Nations (FAO), the United Nations Environment Programme (UNEP) and the World Organisation for Animal Health (WOAH), to continue working with Member States on efforts to address AMR and to adopt the WHO strategic and operational priorities to address drug-resistant bacterial infections in the human health sector, 2025-2035, the release also said. (ANI)
(The above story is verified and authored by ANI staff, ANI is South Asia's leading multimedia news agency with over 100 bureaus in India, South Asia and across the globe. ANI brings the latest news on Politics and Current Affairs in India & around the World, Sports, Health, Fitness, Entertainment, & News. The views appearing in the above post do not reflect the opinions of LatestLY)













 Quickly
Quickly